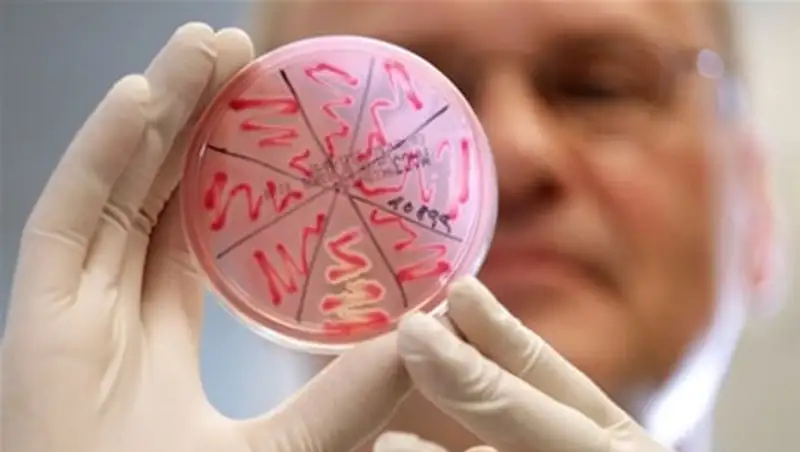

У 27 детей в Алматы обнаружена острая кишечная инфекция
Zakon.kz
Zakon.kz
Зарегистрированы 2 случая вирусного гепатита А среди взрослых.
В Алмате за минувшую неделю зарегистрировано 27 случаев острых кишечных инфекций среди детей до 14 лет, 6 случаев сальмонеллеза. Об этом сообщается на сайте городского Департамента по защите прав потребителей.
Установлено, что в 87,5% случаев заболеваемость связана с употреблением продуктов питания, приготовленных и хранившихся в домашних условиях. Зарегистрированы 2 случая вирусного гепатита А среди взрослых.
«Всего за неделю обследовано 50 объектов, выявлено 10 объектов с отступлением от санитарных правил, наложено 74 штрафа на сумму 1 007 488 тенге, удержано 59 штрафов на сумму 1 076 012 тенге, выдано 8 предписаний, отстранено от работы 4 человека», - говорится в распространенном сообщении.
Материалы переданы в экономический суд на приостановление деятельности трех объектов в Алатауском и Бостандыкском районах.
Поделитесь новостью
Читайте также
Если вы видите данное сообщение, значит возникли проблемы с работой системы комментариев. Возможно у вас отключен JavaScript












